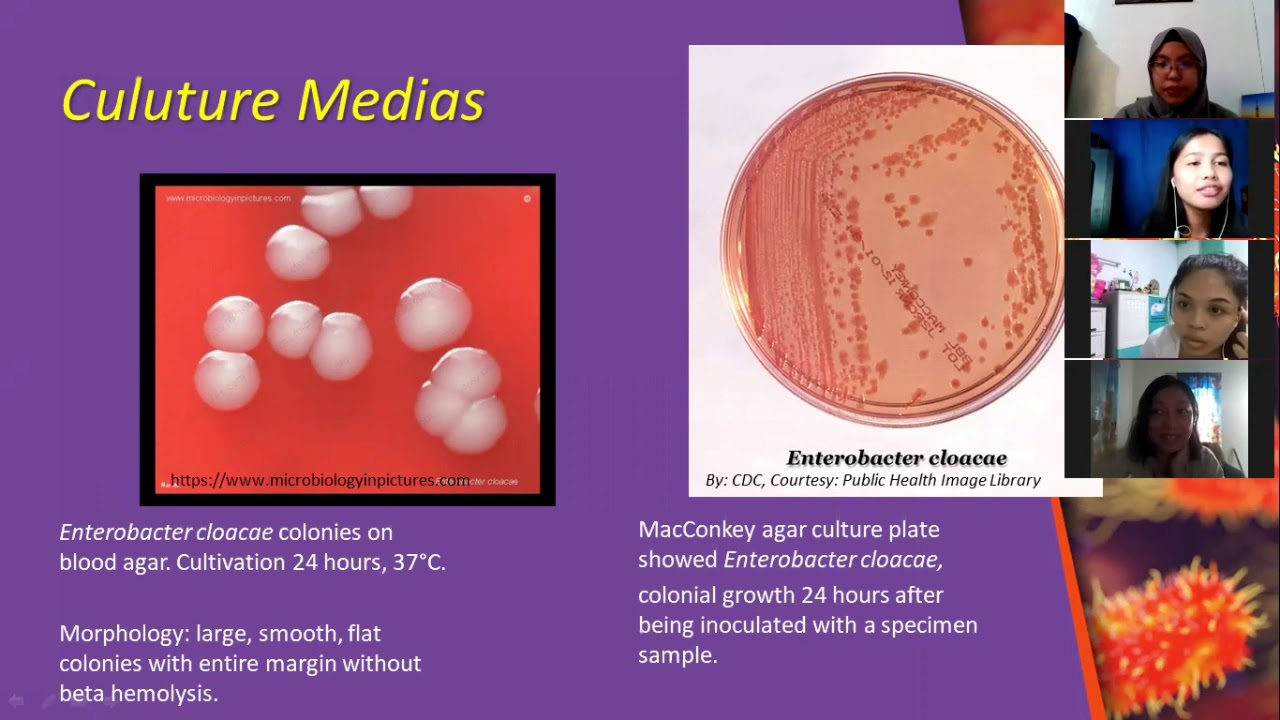
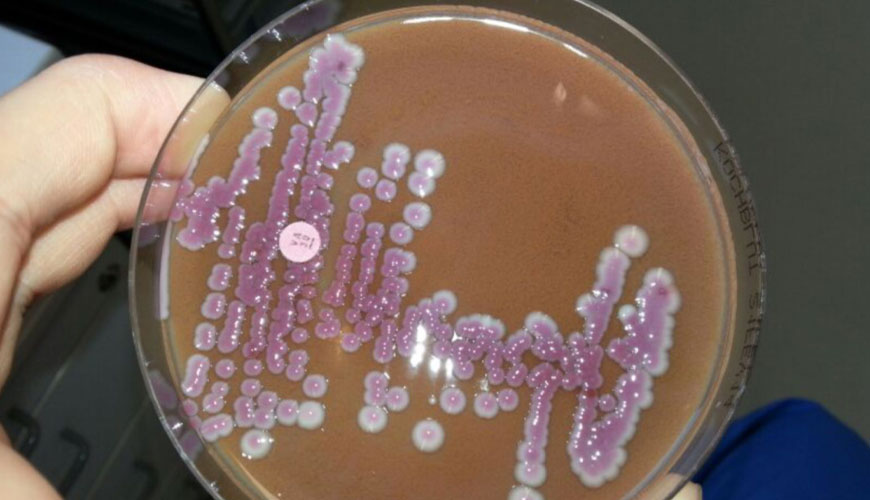

Enterobacter cloacae у взрослого
Enterobacter cloacae у взрослого 111 фото
Абаканские колледжи после 11 класса
Расписание а113 на завтра
Everyone wants to rule
Get started in crypto тапсвап
Как определить тромб у человека
Сальник винтового компрессора
Стихи алине короткие
Sssiyans collaborative cheat trainer
Безымянный объяснение написания
Ван ту игра